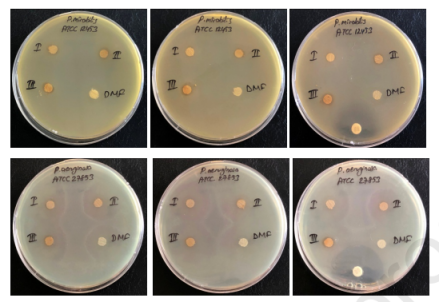

DOI:10.1016/j.apsusc.2020.146332
静电纺丝是一种在不同领域生产聚合物和金属氧化物纳米纤维的有前途的技术。在这项工作中,将不同重量比(5%、7.5%和10%)的Fe3O4@Cs@Ag磁性纳米粒子添加到PVP(聚乙烯吡咯烷酮)聚合物中,并通过静电纺丝法制备了磁性纳米纤维(MNFs)。对所制备的纳米纤维的结构、磁性、形态、光谱和热性能进行了表征。此外,研究了Fe3O4@Cs@Ag纳米纤维膜的抗菌作用。所获得的SEM图像显示制备的纳米纤维是均匀且无缺陷的。此外,通过X射线衍射仪和振动样品磁力计测试纤维的结晶度和磁矩。结果表明,制备的纳米纤维膜对金黄色葡萄球菌、枯草芽孢杆菌、粪肠球菌、大肠杆菌、奇异变形杆菌和铜绿假单胞菌具有良好的抗菌活性。

图1.Fe3O4@Cs@Ag纳米复合材料的FT-IR光谱。

图2.(a)Fe3O4@Cs纳米复合材料、Fe3O4@Cs@Ag磁性纳米复合材料和Fe3O4@Cs@Ag MNFs的FT-IR光谱(5%、7.5%和10%);(b)Fe3O4@Cs@Ag磁性纳米纤维的XRD图谱(5%、7.5%和10%)。

图3.Fe3O4@Cs纳米复合材料、Fe3O4@Cs@Ag磁性纳米复合材料和Fe3O4@Cs@Ag MNFs的TGA热分析图(5%、7.5%和10%)。



图4.含(a)5%、(b)7.5%和(c)10%Fe3O4@Cs@Ag的磁性纳米纤维的SEM图像。

图5.含(a)5%、(b)7.5%和(c)10%Fe3O4@Cs@Ag的磁性纳米纤维的EDX光谱。

图6.含5%、7.5%和10%Fe3O4@Cs@Ag的磁性纳米纤维中Ag和Fe的量。


图7.(a)样品1(b)样品2(c)样品3在300K下的磁化强度与磁场测量的关系。(a)、(b)和(c)图的插图显示矫顽力分别为20Oe、20Oe和25Oe。(d)显示了3T(30kOe)和-3T(30kOe)之间的组合磁滞曲线,(e)显示了去除PVP顺磁性部分后的磁滞曲线。

图8.含3种不同浓度Fe3O4@Cs@Ag磁性纳米纤维(5%、7.5%和10%)的人造纳米纤维对六种不同细菌的抗菌活性。还测试了用于制备纳米纤维的DMF和Fe3O4@Cs@Ag溶液作为对照的抗菌活性。